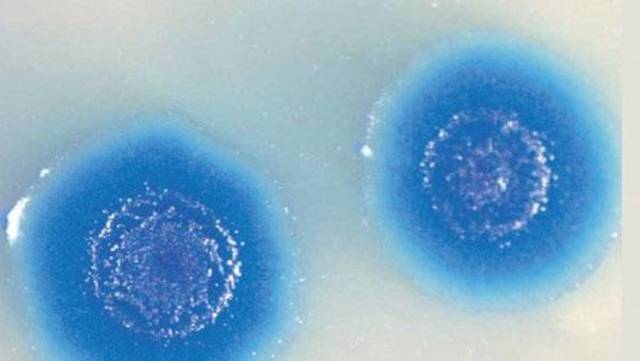
CÉLULAS SINTETICAS

¿Cómo las tecnologías emergentes a través de la historia ha contribuido en nuestro país durante los últimos 20 años en la sociedad cambiante?
-
Activacion del servicio de telefono en Bogota
-
-
Conexion de la primera linea a larga distancia telefónica entre Bogota y Medellin
-
-
La empresa ERICCSON agrega el sistema de fibra óptica en las comunicaciones de Bogota
-
Tim Berners-Lee lanzó el primer y especial sitio web público de la red que aún hoy se utiliza , la WWW como un servicio disponible públicamente en Internet y se puso a disposición de todos las bases del proyecto aunque los que contaban con un navegador web eran pocos para ese tiempo.
-
La primera web activa de internet en colombia fue edu.co y fue la de la Universidad de los Andes y algunos días después estaban las de la Universidad del Valle y la EAFIT, así como la de Telecom que registró uno de los primeros .net.co.
-
Se inicio el servicio de telefonía celular.Ademas se inauguro en Bogota, Medellin y Cali la primera fase de la RDSI de banda ancha.
-
Es es lanzamiento más publicitado que Microsoft haya realizado con soporte técnico de Internet integrado, acceso telefónico a redes, y nuevas capacidades de Plug and Play que hacen que sea fácil instalar hardware y software.
-
Llega la primera cámara y sus primeros modelos fueron DC20 y DC25, de Kodak, y PhotoPC de Epson. Las memorias iban de 1 a 2 MB (para almacenar hasta 29 imágenes en resolución estándar).
-
Es la primera versión de Windows diseñada específicamente para los consumidores.
-
Telecom popularizo la conexión a Internet en el país.
-
Orbitel y la ETB arrancaron oficialmente la competencia por este mercado ,los medios estuvieron inundados por pegajosas campañas de publicidad que invitaban a los colombianos a marcar por el 005, 007 y 009.
-
-
-
-
-
-
-
-
-
-
-
-
-
-
-
-
A list shows items. A timeline shows sequence.
Use Timetoast to make dates, milestones, and turning points easier to understand in a clear visual format. Timetoast is a timeline maker for work, school, research, and stories.